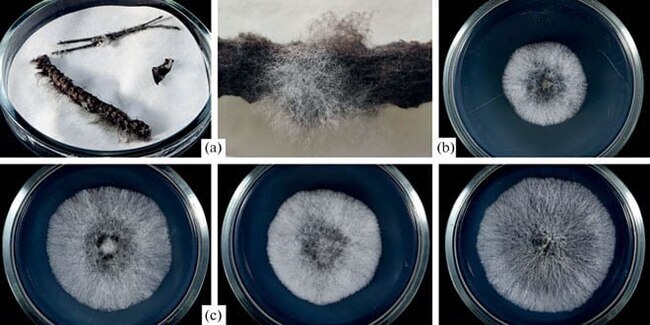

Ответ на пост «Дом в Предлесье»1
Хочу! Как же я хочу! ПОДКРАСТЬСЯ НОЧЬЮ И ПОДЖЕЧЬ ЭТОТ СЛАВНЫЙ ДОМИШКО! Уверен, там живут замечательные люди, а может гномы? В любом случае, очевидно, что обитатели это настоящие божьи одуванчики, о, как же я хочу разрушить их славную идиллию и упиваться криками, пожираемых пламенем.
А потом я подговорю партию, что мы должны найти виновников этого ужасного злодеяния, и сам подброшу нужные улики. Так я поведу их по маршруту, который нужен только мне и натравлю на своих заклятых врагов, которые однажды помешали моим планам. Они заплатят за то, что сделали со мной! Все они заплатят!
Ну а затем моим финальным аккордом станет благодарность. Искренняя благодарность моим новым лучшим друзьям. Которые мне больше не нужны. Никто ведь не станет проверять на привале еду на наличие яда? Вы были полезны, теперь умрите.
Пы.сы. Я тут задумался. А кто-нибудь пытался совместно с игроком провернуть что-нибудь подобное? В смысле сделать предательство персонажа одной из основных сюжетных развилок, которую игрокам (которым ничего не сообщается) необходимо раскусить ложь и избавиться от предателя до того, как он избавится от них.